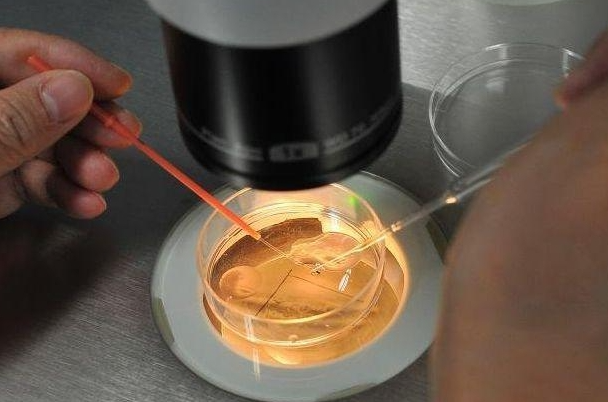
7a7c53d3765af5fdd6823ad8d6f5bced.png 深圳市妇幼保健院试管三代需要87412.64元吗

深圳市妇幼保健院一直以来致力于为广大患者提供全面的妇幼保健服务,其中试管婴儿技术作为辅助生育的重要手段之一,备受关注。在这座现代化城市中,妇幼保健院的试管医生名单及费用问题成为许多家庭关心的焦点。然而,由于医院政策和医生团队的变动,具体的医生名单和费用信息可能随时发生变化。因此,建議患者在咨詢時直接聯系深圳市婦幼保健院,或瀏覽其官方網站以獲取最新的醫生名單和相關費用信息。接下来我们就去看看,深圳市妇幼保健院试管医生名单,深圳市妇幼保健院试管三代需要87412.64元吗?

深圳市妇幼保健院试管医生排名
1、李雪梅(主任医师):专注于深入研究生殖内分泌疾病和不孕症的诊治,拥有丰富的临床经验和实验室胚胎培养经验。
2、傅志红(主任医师):对多囊卵巢综合征、子宫内膜异位症、卵巢功能下降引起的不孕症具有独特的认识。
3、秦春荣(主任医师):擅长不孕和妇科内分泌,尤其在辅助生殖技术的安全性和个性化超促排卵方案方面表现突出。
4、刘大雁(主任医师):具备丰富的临床经验,熟练于试管婴儿、人工授精、不孕、多囊卵巢综合征、促排卵治疗、卵泡监测等领域。
5、邓天勤(副主任医师):擅长人工授精,专注于调理试管婴儿前精子质量。
深圳市妇幼保健院试管婴儿怎么样
深圳市妇幼保健院生殖中心成立于1999年,汇聚了多名富有经验的生殖医学专家和医务人员。該中心引領一、二、三代試管嬰兒技術,其中一代和二代試管的成功率達到50%左右,而三代试管的成功率更高,可达到60%左右。此外,生殖中心还提供一系列辅助生殖技术,如人工授精、卵泡监测、基因检测等,致力于助力不孕不育家庭实现生育梦想。
深圳妇幼保健院试管婴儿可以做双胞胎吗
深圳妇幼保健院试管婴儿是可以选择做双胞胎的,其过程包括将有活力的精子和卵子在试管内结合形成胚胎,然后将胚胎移植到子宫内。是否选择做双胞胎主要取决于女性移植后胚胎的着床成功率。医生可以同时放置两个以上的胚胎,但胚胎生长是否能够存活具有不确定性。移植多个胚胎可能导致只有一个胚胎存活或多个胚胎着床,形成多胞胎情况。
深圳妇幼保健院做三代试管多少钱
深圳市妇幼保健院生殖中心提供的三代试管婴儿费用约为6-8万元,但具體費用會因個體情況而異。費用涵蓋了檢查、藥物和手術等方面的開支。促排卵藥物費用較高,而胚胎筛选费用也是其中的重要组成部分。胚胎筛查数量增多可能导致费用上升,一般情况下可在10万元左右。
”深圳市妇幼保健院试管医生名单,深圳市妇幼保健院试管三代需要87412.64元吗?“深圳市妇幼保健院作为一家具备丰富经验和先进技术的医疗机构,为患者提供了试管婴儿等多方面的专业服务。在面对试管医生名单和费用问题时,建议患者及时与医院联系,获取最新的信息,并在明确个人需求的基础上,选择合适的医生和医疗方案,为实现健康生育梦想奠定坚实的基础。
